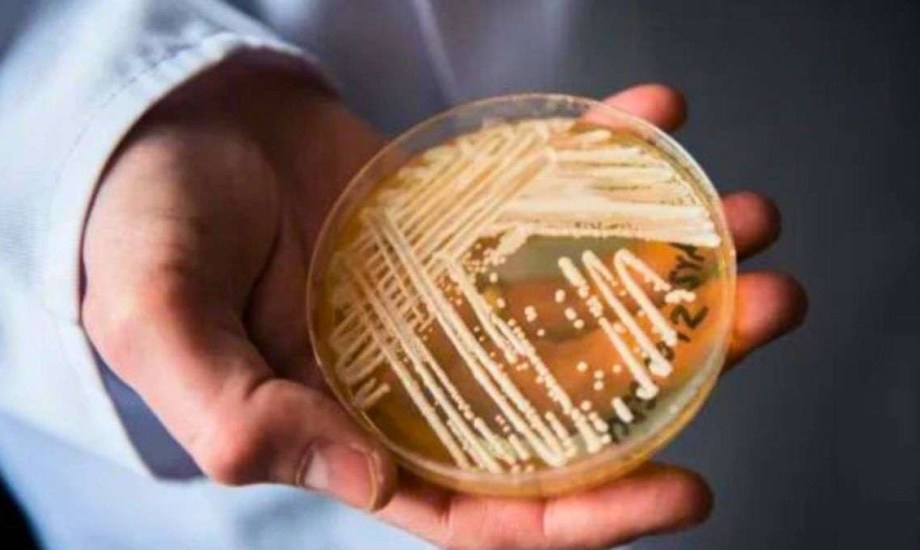
عدوى فطرية خطيرة تنتشر في المستشفيات والعيادات

كانديدا أوريس.. عدوى فطرية خطيرة تنتشر في المستشفيات والعيادات
تعد بعض أنواع العدوى والفطريات من المشكلات الصحية الخطيرة التي قد تنتقل بين الأفراد دون ظهور أعراض واضحة، ما يجعل الشخص حاملاً للمرض دون أن يدرك ذلك، ومن أبرز هذه العدوى فطر كانديدا أوريس، المعروف أيضاً باسم فطريات المبيضات أوريس، والذي ينتشر بشكل خاص في البيئات الطبية مثل المستشفيات والعيادات، وكذلك عبر الأدوات والمعدات الطبية.
وفي السطور التالية تستعرض "بوابة صحة" كل ما تحتاج معرفته عن عدوى كانديدا أوريس، بدءاً من طرق انتقالها وصولاً إلى أعراضها والفئات الأكثر عرضة للإصابة بها، بهدف رفع الوعي الصحي وتعزيز التدابير الوقائية.
ما هي عدوى كانديدا أوريس؟
عدوى كانديدا أوريس (Candida auris) هي عدوى فطرية خطيرة تُصيب الإنسان، وتنتشر بشكل رئيسي في المرافق الصحية مثل المستشفيات ودور الرعاية، ويمكن أن تسبب التهابات في عدة أجزاء من الجسم، بما في ذلك الأذن والمسالك البولية، كما قد تؤدي إلى عدوى مجرى الدم التي تشكل خطراً كبيراً على الصحة، حسب Cleveland Clinic.
 ما هي عدوى كانديدا أوريس؟
ما هي عدوى كانديدا أوريس؟
ما أعراض الإصابة بعدوى كانديدا أوريس؟
تشمل الأعراض الرئيسية لعدوى كانديدا أوريس ما يلي:
-ارتفاع درجة الحرارة (الحمى)
-القشعريرة والارتجاف
-الإرهاق الشديد والخمول
-صعوبة في ممارسة الأنشطة اليومية المعتادة
-انخفاض ملحوظ في ضغط الدم
-تسارع في معدل ضربات القلب
-ألم أو ضغط شديد في الأذن (في حالات إصابة الأذن)
كيف تنتقل عدوى كانديدا أوريس؟
تنتقل العدوى بشكل أساسي من خلال التلامس المباشر مع شخص مصاب، أو لمس الأسطح أو المعدات الطبية الملوثة في مرافق الرعاية الصحية، أو استخدام أجهزة طبية ملوثة مزروعة في جسم المريض، مثل الأنابيب الوريدية أو أنابيب التنفس.
ومن الجدير بالذكر أن فطر كانديدا أوريس لا ينتقل عبر الهواء، كما أن الأفراد الأصحاء الذين لا يعانون من مشكلات مناعية نادراً ما يصابون بهذه العدوى.
الفئات الأكثر عرضة لعدوى كانديدا أوريس
تزداد خطورة الإصابة بعدوى كانديدا أوريس لدى الفئات التالية:
 الفئات الأكثر عرضة لعدوى كانديدا أوريس
الفئات الأكثر عرضة لعدوى كانديدا أوريس
1-ذوو المناعة الضعيفة:
-المرضى الذين يتلقون علاجاً كيميائياً
-المصابون بفيروس نقص المناعة البشرية (HIV)
-متلقو زراعة الأعضاء
2-المرضى الذين يستخدمون الأجهزة الطبية المزروعة:
-أنابيب الوريد المركزية
-أنابيب التنفس الصناعي
-أنابيب التغذية
-قساطر المثانة
3-مرضى الأمراض المزمنة:
-المصابون بالسكري غير المنضبط
-مرضى الأورام الدموية الخطيرة (مثل اللوكيميا)
4-المرضى في المرافق الصحية:
-الذين خضعوا لعمليات جراحية حديثاً
-المقيمون لفترات طويلة في وحدات العناية المركزة
-المرضى الذين يتلقون رعاية صحية مكثفة
5-مستخدمو المضادات الحيوية بانتظام:
-الذين يتناولون مضادات حيوية واسعة الطيف لفترات طويلة
-المرضى الذين يتلقون علاجات متعددة بالمضادات الحيوية